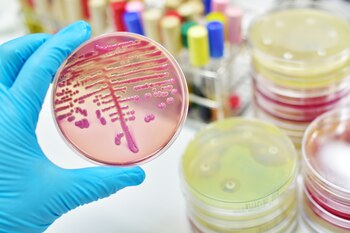
Los autores del estudio señalaron que las diferencias observadas en la diversidad microbiana y en las vías metabólicas de los niños sugieren que los patrones de sueño influyen de manera significativa en la microbiota intestinal y la salud cognitiva (Getty)

Un estudio llevado a cabo por el Departamento de Rehabilitación Infantil de China encontró una relación entre la hora en que los niños se acuestan y la salud de su microbiota intestinal.
El trabajo, que fue publicado en Scientific Reports bajo el título “Características de la flora intestinal en niños que se acuestan temprano frente a los que se acuestan tarde”, analizó muestras fecales de 88 niños sanos, con edades comprendidas entre los 2 y 14 años.
La investigación planteó que aquellos niños que se acuestan temprano presentan una mayor diversidad microbiana en su flora intestinal, lo que sugiere que los hábitos de sueño pueden tener un impacto directo en la salud digestiva y cognitiva, de acuerdo al hallazgo.
Los participantes fueron divididos en dos grupos según su hora de dormir: el primero incluía a quienes se acostaban antes de las 21:30, mientras que el segundo estaba compuesto por chicos que dormían después de esa hora. Durante dos semanas, los investigadores registraron varios parámetros del sueño, tales como el tiempo que tardaban en dormirse, la cantidad de despertares nocturnos y la calidad general del descanso.

El análisis realizado a las muestras fecales mostró que los niños que se acostaban temprano tenían una mayor abundancia de bacterias intestinales beneficiosas, particularmente de la especie Akkermansia muciniphila. Según el estudio, “estas bacterias están asociadas con el mantenimiento de la salud intestinal y se vinculan con funciones cognitivas saludables”.
Además de Akkermansia muciniphila, otras bacterias benéficas que se encontraban en mayor cantidad en los niños que dormían temprano incluían a Holdemania filiformis, Firmicutes bacteria CAG-95, Streptococcus sp. A12, Weissella confusa, Clostridium sp. CAG-253, Alistipes finegoldii y Eubacterium siraeum. También se observaron niveles más altos del hongo CAG-83 en este grupo. A nivel de filo y género, las especies de Verrucomicrobia, Akkermansia, Holdemania y Firmicutes no clasificado mostraron una mayor presencia en los niños con patrones de sueño más tempranos.
Un aspecto importante de la investigación fue la correlación entre las métricas del sueño y las especies microbianas. Se descubrió que Akkermansia muciniphila y Alistipes finegoldii estaban positivamente relacionadas con el tiempo que los niños tardaban en conciliar el sueño. Sin embargo, la especie Clostridium sp. CAG-253 mostró una correlación negativa con este mismo parámetro. Por otro lado, Alistipes finegoldii también se asoció positivamente con la duración total del sueño, aunque de manera negativa con la eficiencia del sueño y la frecuencia de los sueños.
El estudio también postuló que el metabolismo de los aminoácidos y la regulación de neurotransmisores eran más activos entre los niños que se acostaban temprano. Estas vías metabólicas son esenciales para el desarrollo y la función cerebral, lo que refuerza la idea de que el sueño puede influir tanto en la salud intestinal como en la cognición, de acuerdo con los expertos.
Según los autores, estas diferencias en la diversidad de especies y en las vías metabólicas sugieren que los patrones de sueño influyen significativamente en la microbiota intestinal.
Aunque el estudio identificó correlaciones claras entre los patrones de sueño y la microbiota, los investigadores advirtieron que aún no se ha establecido una relación de causalidad definitiva. Es posible que los hábitos de sueño estén influyendo en la composición microbiana del intestino, o viceversa, que la microbiota esté afectando la calidad del sueño.
Para los investigadores, los hallazgos pueden conducir a nuevas intervenciones farmacológicas dirigidas a los trastornos del sueño en los niños, lo que abre la puerta a futuras investigaciones en este campo.

Otro de los puntos destacados del trabajo fue que los horarios de sueño de los niños no fueron intervenidos por los investigadores. En cambio, se respetaron los patrones regulares de cada niño, lo que permite observar las correlaciones de manera más natural. Esto refuerza la relevancia de los hallazgos, ya que no se introdujeron modificaciones externas que pudieran influir en los resultados.
El descubrimiento de que las bacterias intestinales pueden tener una relación con la calidad del sueño plantea preguntas intrigantes sobre cómo se relacionan el sueño, la salud intestinal y el rendimiento cognitivo. Los expertos sugirieron que estas correlaciones podrían abrir caminos para futuras investigaciones orientadas a desentrañar los mecanismos causales detrás de la conexión entre el sueño y el intestino, así como su posible impacto en la función cerebral.
0 Comentarios